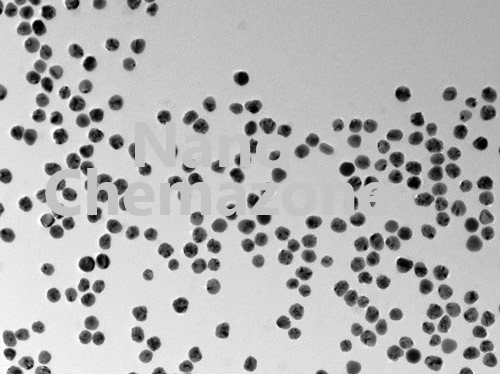

Gold Nanoparticles
$0.00
Gold Nanoparticles
| MF: | Au |
| Chemical Name: |
Gold Nanoparticles |
| Purity: | > 99.99% |
| APS: | 30-40 nm (Size Customization possible) |
| Form: | Nanopowder/Dispersion |
| Product Number: | #NCZ2901 |
| CAS Number | 7440-57-5 |
Note: We supply different products of microparticles and Nanoparticles powder in all sizes range according to the client’s requirements.
Category: Nanoparticles & Nanopowders
Description
Note: For pricing & ordering information, please contact us at sales@nanochemazone.com
Please contact us for quotes on Larger Quantities & Customization. E-mail: contact@nanochemazone.com
Customization:
If you are planning to order large quantities for your industrial and academic needs, please note that customization of parameters (such as size, length, purity, functionalities etc.) are available upon request.
Shipping & Delivery
Related products
Alumina nanoparticles powder
$0.00
Alumina nanoparticles powder
| MF: | Al2O3 |
| Chemical Name: | Aluminum Oxide Nanoparticle Powder |
| Purity: | > 99.99% |
| APS: | 20-100 nm (Customization is possible) |
| Form: | Nanopowder/Dispersion |
| Product Number: | NCZ2201-G |
| CAS Number | 1344-28-1 |
Alumina nanoparticles powder
The aluminum Oxide gamma form is also available on request. Note: We can supply different size products of microparticles and Nanoparticles Size range powder according to the client’s requirements.Barium Sulfate (BaSO4) Nanoparticles
$0.00
Barium Sulfate Nanoparticles
| MF: | BaSO4 |
| Chemical Name: | Barium Sulfate |
| Purity: | > 99.99% |
| APS: | 200-500 nm (Size Customization possible) |
| Form: | Nanopowder |
| Product Number: | #NCZ701 |
| CAS Number | 7727-43-7 |
Barium Sulfate Nanoparticles
Note: We can supply different size products of microparticles and Nanoparticles Size range powder according to the client’s requirements.Boron Carbide nanoparticles
$0.00
Boron carbide nanoparticles
Boron carbide nanopowder
Nano Boron carbide Powder
| MF | B4C |
| Chemical Name | Boron carbide nanoparticles |
| Purity | > 99.99% |
| APS | 80 nm (Size Customization possible) |
| Form | Nanopowder |
| Product Number | #NCZ901 |
| CAS Number | 12069-32-8 |
Copper Nanoparticles
$0.00
Copper Nanoparticles Powder
| MF: | Cu |
| Chemical Name: |
Copper Nanoparticles |
| Purity: | > 99.99% |
| APS: | 25 nm (Size Customization possible) |
| Form: | Nanopowder/Dispersion |
| Product Number: | #NCZ2101 |
| CAS Number | 7440-50-8 |
Application:
The key applications of copper nanoparticles are listed below:
Copper nanoparticles based ink for screen printed circuits and electrode fabrication for electrochemistry.
Acts as an antibiotic, anti-microbial, and anti-fungal agent when added to plastics, coatings, and textiles. Copper diet supplements with efficient delivery characteristics. High strength metals and alloys.
Copper plays an important role in electronic circuits because of its excellent electrical conductivity and ideal material for Thermal, electronic, and biomedical applications such as antimicrobial, Dental Health care and antiviral mask, and gloves coating.
Please contact us for customization and price inquiry.
Note: We supply different size products of micro and Nano Size range dispersion according to the client’s requirements.
Dysprosium Oxide Nanoparticles
$0.00
Dysprosium Oxide Nanoparticles
Dysprosium Oxide Nanopowder
Nano Dysprosium Oxide
| MF: | Dy2O3 |
| Chemical Name: | Dysprosium Oxide |
| Purity: | > 99.99% |
| APS: | 20 nm (Size Customization possible) |
| Form: | Nanopowder |
| Product Number: | #NCZ2501 |
| CAS Number | 1308-87-8 |
Hafnium Oxide Nanoparticles
$0.00
Hafnium Oxide Nanoparticles
Hafnium Oxide Nanopowder
Nano Hafnium Oxide
| MF | HfO2 |
| Chemical Name | Hafnium Oxide |
| Purity | ≥ 99.99% |
| APS | 50-100 nm (Size Customization possible) |
| Form | Nanopowder |
| Product Number | NCZ3201 |
| CAS Number | 12055-23-1 |
Indium Hydroxide Nanoparticles
$0.00
Indium Hydroxide Nanoparticles
Nano Indium Hydroxide powder
Indium Hydroxide nanopowder
| MF: | In(OH)3 |
| Chemical Name: | Indium Hydroxide |
| Purity: | > 99.99% |
| APS: | 55 nm (Size Customization possible) |
| Form: | Nanopowder |
| Product Number: | #NCZ3301 |
| CAS Number | 20661-21-6 |
Iron oxide nanoparticles
$0.00
Iron Oxide Nanoparticles
Iron Oxide Nanopowder
| MF: | Fe2O3, alpha |
| Chemical Name: | Iron Oxide |
| Purity: | > 99.99% |
| APS: | 60 nm (Size Customization possible) |
| Form: | Nanopowder and Rod Shape |
| Product Number: | #NCZ3702 |
| CAS Number | 1309-37-1 |